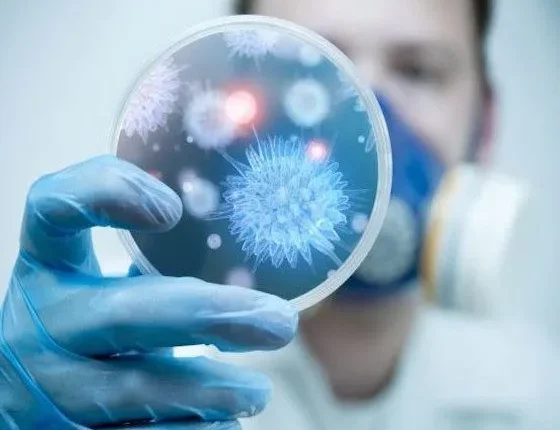

Κοροναϊός: Πόσο ανησυχητικές είναι οι τρεις νέες μεταλλάξεις;
Οι νέες παραλλαγές των μεταλλάξεων του κοροναϊού έχουν δημιουργήσει τεράστια ανησυχία στην παγκόσμια κοινότητα, καθώς ακόμα δεν είναι γνωστός ο βαθμός της επικινδυνότητάς τους και είναι μεγάλος ο φόβος μήπως μπορούν να τινάξουν στον αέρα το παγκόσμιο εμβολιαστικό πρόγραμμα.
Σύμφωνα με όσα είναι γνωστά μέχρι στιγμής, τα νέα στελέχη του κοροναϊού είναι πιο μεταδοτικά από τον κοροναϊό που ξεκίνησε την πανδημία.
H επιστήμη καλεί μάλιστα σε άμεση διερεύνηση των μεταλλάξεων, ώστε να κατανοήσουμε καλύτερα τη φύση τους.
Μέχρι και σήμερα, έχουμε μια νέα παραλλαγή στην Αγγλία, η οποία φαίνεται να κυριαρχεί πια στη χώρα και να έχει εξαπλωθεί σε περισσότερα από 50 κράτη. Υπάρχει, επίσης, μια νέα παραλλαγή στη Νότια Αφρική, η οποία εντοπίστηκε σε τουλάχιστον 20 χώρες (και τη Βρετανία), καθώς και ένα νέο στέλεχος στη Βραζιλία.
Κι ενώ οι επιστήμονες ανέμεναν και αναμένουν μεταλλάξεις του κοροναϊού, καθώς κάτι τέτοιο είναι φυσικό στον κόσμο των ιών, ανησυχούν για την πιο μεταδοτική φύση των τριών αυτών παραλλαγών. Ο ιός φαίνεται να γίνεται καλύτερος στη μόλυνση των ανθρώπινων κυττάρων και τη διασπορά του.
Οι ειδικοί εκτιμούν πως η μετάλλαξη της Αγγλίας που εντοπίστηκε τον Σεπτέμβριο μπορεί να είναι ακόμα και 70% πιο μολυσματική. Η έρευνα της Public Health England την τοποθετεί κάπου μεταξύ 30-50%. Είναι η παραλλαγή που έφερε τα νέα lockdown της Αγγλίας.
Η παραλλαγή της Νότιας Αφρικής αναδύθηκε ερευνητικά τον Οκτώβριο και παρουσιάζει τις μεγαλύτερες μεταλλάξεις στο στέλεχος του ιού. Αυτή φέρει μάλιστα αλλοιώσεις που ίσως επηρεάσουν την αποτελεσματικότητα των εμβολίων που κυκλοφορούν.
Η παραλλαγή της Βραζιλίας εμφανίστηκε τον Ιούλιο και μοιάζει αρκετά με αυτή της Νότιας Αφρικής.
Τα εμβόλια έχουν σχεδιαστεί με βάση τις παλιότερες μορφές του κοροναϊού, η επιστήμη μάς καθησυχάζει ωστόσο πως η αποτελεσματικότητα των σκευασμάτων δεν κινδυνεύει για την ώρα από τα νέα στελέχη.
Λέει όμως πως χρειάζονται περισσότερες έρευνες ώστε να ξεκαθαριστεί αυτό το ζήτημα.
Τέλος, για την ώρα δεν υπάρχουν δεδομένα που να υποδεικνύουν πως οι νέες παραλλαγές προκαλούν σοβαρότερης μορφής μόλυνση.
